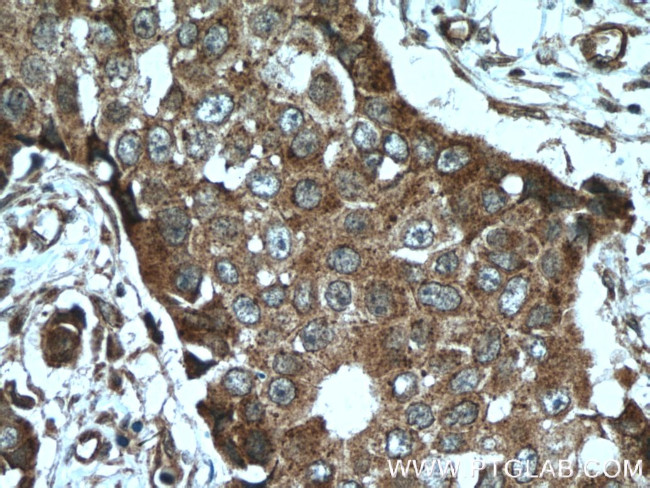
TRPC4AP Antibody in Immunohistochemistry (Paraffin) (IHC (P))
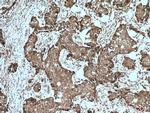
TRPC4AP Antibody in Immunohistochemistry (Paraffin) (IHC (P))

Search
Proteintech
TRPC4AP Polyclonal Antibody
{{$productOrderCtrl.translations['antibody.pdp.commerceCard.promotion.promotions']}}
{{$productOrderCtrl.translations['antibody.pdp.commerceCard.promotion.viewpromo']}}
{{$productOrderCtrl.translations['antibody.pdp.commerceCard.promotion.promocode']}}: {{promo.promoCode}} {{promo.promoTitle}} {{promo.promoDescription}}. {{$productOrderCtrl.translations['antibody.pdp.commerceCard.promotion.learnmore']}}
产品信息
12606-1-AP
种属反应
已发表种属
宿主/亚型
分类
类型
抗原
偶联物
形式
浓度
规格
纯化类型
保存液
内含物
保存条件
运输条件
产品详细信息
Immunogen sequence: VAAWGGWGG RPRPGNILLQ LRQGQLTGRG LVRAVQFTET FLTERDKQSK WSGIPQLLLK LHTTSHLHSD FVECQNILKE ISPLLSMEAM AFVTEERKLT QETTYPNTYI FDLFGGVDLL VEILMRPTIS IRGQKLKISD EMSKDCLSIL YNTCVCTEGV TKRLAEKNDF VIFLFTLMTS KKTFLQTATL IEDILGVKKE MIRLDEVPNL SSLVSNFDQQ QLANFCRILA VTISEMDTGN DDKHTLLAKN AQQKKSLSLG PSAAEINQAA LLSIPGFVER LCKLATRKVS ESTGTASFLQ ELEEWYTWLD NALVLDALMR VANEESEHNQ (22-350 aa encoded by BC013144)
靶标信息
Substrate-specific adapter of a DCX (DDB1-CUL4-X-box) E3 ubiquitin-protein ligase complex required for cell cycle control. The DCX(TRUSS) complex specifically mediates the polyubiquitination and subsequent degradation of MYC. Also participates in the activation of NFKB1 in response to ligation of TNFRSF1A, possibly by linking TNFRSF1A to the IKK signalosome. Involved in JNK activation via its interaction with TRAF2. Also involved in elevation of endoplasmic reticulum Ca(2+) storage reduction in response to CHRM1.
仅用于科研。不用于诊断过程。未经明确授权不得转售。
生物信息学
蛋白别名: protein phosphatase 1, regulatory subunit 158; Protein TAP1; Protein TRUSS; Rabex-5/Rin2-interacting protein; Short transient receptor potential channel 4-associated protein; TAP1 protein; TNF-receptor; TNF-receptor ubiquitous scaffolding/signaling protein; TP4AP; transient receptor protein 4, associated protein; TRP4-associated protein; Trp4-associated protein TAP1; trpc4-associated protein; tumor necrosis factor receptor-associated ubiquitous scaffolding and signaling protein; unnamed protein product
基因别名: 4833429F06Rik; C20orf188; D2Ertd113e; mFLJ00177; PPP1R158; TRPC4AP; TRRP4AP; TRUSS
UniProt ID: (Human) Q8TEL6, (Mouse) Q9JLV2
Entrez Gene ID: (Human) 26133, (Rat) 362247, (Mouse) 56407